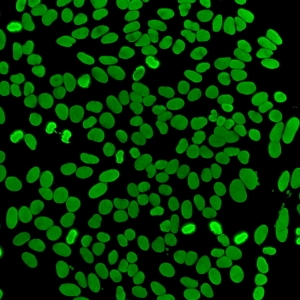

روش انجام آزمایش ANA — آزمایش آنتیبادیهای ضد هسته (ANA) با روش ایمونوفلورسانس غیرمستقیم (IIF) روی سلولهای HEp-2: راهنمای جامع برای کارشناسان آزمایشگاه
خلاصه : روش انجام آزمایش ANA با تکنیک ایمونوفلورسانس غیرمستقیم (IIF) روی سلولهای HEp-2،به استاندارد طلایی برای غربالگری اتوآنتیبادیهای ضدهستهای است . روش انجام آزمایش ANA به این شرح است که سلول های بیمار با این روش حساسیت بالایی دارد و امکان شناسایی الگوهای فلورسانس مرتبط با بیماریهای خودایمنی را فراهم میکند.
جهت عضویت در کانال آموزشی در تلگرام به لینک زیر مراجعه کنید:
https://t.me/hematology_education
فهرست مطالب:
آزمایش آنتیبادیهای ضد هسته (ANA) با روش ایمونوفلورسانس غیرمستقیم (IIF) روی سلولهای HEp-2: راهنمای جامع برای کارشناسان آزمایشگاه
## مقدمه
آزمایش آنتیبادیهای ضد هسته (ANA) با استفاده از روش ایمونوفلورسانس غیرمستقیم (IIF) روی سلولهای HEp-2، استاندارد طلایی برای غربالگری اتوآنتیبادیهای ضدهستهای در تشخیص بیماریهای خودایمنی سیستمیک محسوب میشود. این روش حساسیت بالایی (بیش از 95% برای لوپوس اریتماتوز سیستمیک) دارد و امکان شناسایی طیف وسیعی از الگوهای فلورسانس را فراهم میکند که هر کدام با بیماریهای خاصی مرتبط هستند. این مقاله بر اساس منابع معتبر خارجی مانند مقالات PubMed Central، Medscape و ARUP Consult تهیه شده است و تمرکز آن بر توضیح مفصل روش کار، کاربردها و تفسیر نتایج است.
## روش انجام آزمایش ANA بر اساس ایمونوفلورسانس غیرمستقیم (IIF) با استفاده از سلولهای HEp-2
روش IIF روی سلولهای HEp-2 (خط سلولی اپیتلیال انسانی مشتق از کارسینومای حنجره) بر اساس اصول ایمونولوژیکی اتصال آنتیبادیهای بیمار به آنتیژنهای هستهای سلولها و سپس تشخیص آن با آنتیبادی ثانویه فلورسانت است. این سلولها به دلیل هسته بزرگ و بیان بیش از 150 آنتیژن هستهای و سیتوپلاسمی، سوبسترای ایدئالی هستند. فرآیند به صورت گامبهگام و با جزئیات فنی زیر انجام میشود تا دقت و تکرارپذیری حفظ شود. تمام مراحل باید در شرایط کنترلشده (دما، رطوبت و نور کم برای جلوگیری از محو شدن فلورسانس) انجام گیرد.
### گامهای آمادهسازی اولیه
1. جمعآوری و پردازش نمونه: خون بیمار معمولاً از ورید بازویی گرفته میشود (حجم تقریبی 5-10 میلیلیتر). نمونه در لولههای بدون ضد انعقاد (مانند لولههای سرم) قرار گرفته و اجازه داده میشود تا لخته شود (حدود 30-60 دقیقه در دمای اتاق). سپس، سانتریفیوژ میشود (معمولاً 1500-2000 g برای 10 دقیقه) تا سرم جدا شود. سرم باید شفاف باشد؛ اگر همولیز یا لیپمی وجود داشته باشد، ممکن است نتایج را مختل کند و نیاز به نمونهگیری مجدد باشد. سرم میتواند تا 7 روز در یخچال (4 درجه سانتیگراد) یا طولانیتر در فریزر (-20 درجه) نگهداری شود. هیچ آمادگی خاصی برای بیمار لازم نیست، اما باید داروهای مصرفی (مانند داروهای القاکننده ANA مانند پروکائینآمید یا هیدرالازین) ثبت شود، زیرا میتوانند نتایج را تحت تأثیر قرار دهند.
2. آمادهسازی سوبسترا: سلولهای HEp-2 از پیش ثابتشده (با متانول یا فرمالدئید برای حفظ ساختار هسته) روی اسلایدهای شیشهای (معمولاً 8-12 well در هر اسلاید) قرار میگیرند. این سلولها باید در مرحله میتوز باشند تا الگوهای سانترومری بهتر دیده شوند. کیفیت سوبسترا حیاتی است؛ از تولیدکنندگان معتبر مانند Bio-Rad یا Euroimmun استفاده شود تا تنوع آنتیژنی حفظ شود. اسلایدها باید در دمای اتاق و دور از نور نگهداری شوند تا فلورسانس زمینه کاهش یابد.
### گامهای اصلی آزمایش
3. رقتسازی و اضافه کردن سرم بیمار: سرم بیمار در بافر فسفات سالین (PBS) با pH 7.4 رقیق میشود. رقت اولیه معمولاً 1:40 یا 1:80 است (بر اساس توصیههای ICAP – International Consensus on ANA Patterns). حدود 20-30 میکرولیتر از سرم رقیقشده به هر well اسلاید اضافه میشود. اسلاید سپس در محفظه مرطوب (برای جلوگیری از خشک شدن) انکوبه میشود (معمولاً 20-30 دقیقه در دمای اتاق یا 37 درجه سانتیگراد). در این مرحله، اتوآنتیبادیهای موجود در سرم به آنتیژنهای هستهای، نوکلئولی یا سیتوپلاسمی سلولهای HEp-2 متصل میشوند. اگر نمونه مثبت باشد، اتصال انتخابی رخ میدهد که بعداً الگوهای خاصی ایجاد میکند.
4. شستشوی اولیه: پس از انکوباسیون، اسلاید با PBS شسته میشود (معمولاً 3-5 بار، هر بار 5-10 دقیقه روی شیکر یا به صورت دستی). این گام برای حذف آنتیبادیهای غیرمتصل و کاهش سیگنالهای زمینه ضروری است. شستشو باید ملایم باشد تا سلولها آسیب نبینند، اما کامل تا سیگنالهای کاذب حذف شوند. استفاده از PBS با 0.05% Tween-20 میتواند شستشو را بهبود بخشد.
5. اضافه کردن آنتیبادی ثانویه: آنتیبادی ضد انسانی IgG (یا ترکیبی از IgG/IgM/IgA بسته به کیت) متصل به رنگ فلورسانت مانند فلورسئین ایزوتیوسیانات (FITC) یا رودامین اضافه میشود (حجم 20-30 میکرولیتر). این آنتیبادی باید گونهمخصوص (معمولاً بز یا خرگوش ضد انسانی) باشد. انکوباسیون مجدد در محفظه مرطوب (20-30 دقیقه در دمای اتاق) انجام میشود. در این مرحله، آنتیبادی ثانویه به اتوآنتیبادیهای متصل بیمار متصل شده و کمپلکس فلورسانت تشکیل میدهد.
6. شستشوی ثانویه: مشابه گام 4، اسلاید دوباره شسته میشود تا آنتیبادی ثانویه غیرمتصل حذف شود. این گام حیاتی برای کاهش نویز زمینه است.
7. مونتینگ و بررسی زیر میکروسکوپ: اسلاید با گلیسرول یا مونتینگ مدیوم ضد فیدینگ (مانند DABCO) پوشانده شده و کاوراسلیپ قرار میگیرد. سپس زیر میکروسکوپ فلورسانس (با فیلترهای UV برای FITC، طول موج تحریک 490 nm و انتشار 520 nm) بررسی میشود. بزرگنمایی معمولاً 200-400x است. تکنسین ماهر باید حداقل 50-100 سلول را بررسی کند تا الگوهای فلورسانس، شدت و توزیع را ارزیابی کند. برای نمونههای مثبت، رفتهای سریالی (مانند 1:160، 1:320، 1:640 و بالاتر) انجام شده تا تیتر نهایی تعیین شود. تیتر نقطهای است که شدت فلورسانس به کمتر از نیمی از سلولها کاهش یابد یا الگو محو شود.
### کنترلهای کیفیت
– کنترل مثبت: سرم شناختهشده مثبت (مانند سرم با الگوی هموژن) برای تأیید عملکرد کیت.
– کنترل منفی: سرم سالم یا PBS برای بررسی زمینه.
– کنترلهای داخلی: بررسی سلولهای میتوزی برای الگوهای خاص مانند سانترومر.
هر آزمایشگاه باید پروتکلهای CAP یا ISO 15189 را رعایت کند تا واریانس کاهش یابد.
## کاربردهای آزمایش ANA با روش IIF روی HEp-2
این روش عمدتاً برای غربالگری اولیه در بیماران مشکوک به بیماریهای خودایمنی سیستمیک استفاده میشود، زیرا حساسیت بالایی دارد و میتواند طیف وسیعی از اتوآنتیبادیها را تشخیص دهد. کاربردهای اصلی عبارتند از:
- تشخیص بیماریهای بافت همبند: در لوپوس اریتماتوز سیستمیک (SLE)، بیش از 95% بیماران ANA مثبت هستند، و الگوهای خاص مانند هموژن یا خالدار ریز برای هدایت تشخیصهای افتراقی استفاده میشود. در اسکلرودرمی (اسکلروز سیستمیک)، الگوهای نوکلئولار یا سانترومر شایع هستند و با پیشآگهی مرتبطاند (مانند فرم محدود vs. منتشر). در سندرم شوگرن، الگوهای خالدار درشت (مانند SSA/Ro) مفید است.
- ارزیابی بیماران با علائم غیراختصاصی: در بیمارانی با درد مفاصل مداوم، بثورات پوستی (مانند بثورات پروانهای در SLE)، خستگی مزمن، پدیده رینود، خشکی چشم/دهان یا ضعف عضلانی، این آزمایش برای رد یا تأیید بیماریهای خودایمنی انجام میشود. همچنین در بیماریهای مخلوط بافت همبند (MCTD) یا میوپاتیهای التهابی، الگوهای خاص مانند نوکلئولار برای شناسایی anti-PM-Scl مفید است.
- غربالگری در گروههای پرخطر: در افراد با سابقه خانوادگی خودایمنی، یا بیماران تحت درمان با داروهای القاکننده ANA (مانند داروهای ضد فشار خون یا ضد صرع)، این روش برای نظارت اولیه استفاده میشود. در زنان باردار مشکوک به SLE، تشخیص ANA میتواند خطر سندرم لوپوس نوزادی را ارزیابی کند.
- هدایت آزمایشهای تکمیلی: نتیجه مثبت IIF اغلب منجر به آزمایشهای خاصتر مانند anti-dsDNA، anti-ENA (مانند anti-Sm، anti-RNP) یا anti-centromere میشود. برای مثال، الگوی سانترومر مستقیماً به anti-CENP-B اشاره دارد و نیاز به آزمایشهای تأییدی را کاهش میدهد.
- کاربردهای تحقیقاتی و اپیدمیولوژیک: در مطالعات، این روش برای بررسی شیوع ANA در جمعیتهای سالم (3-15% مثبت کاذب، بیشتر در سالمندان و زنان) استفاده میشود. همچنین در ارزیابی پاسخ به درمان (هرچند نه برای نظارت روتین، زیرا تیترها ممکن است ثابت بمانند).
- کاربرد در بیماریهای غیرروماتیسمی: گاهی در عفونتهای مزمن (مانند هپاتیت C یا EBV)، سرطانها یا بیماریهای کبدی (مانند هپاتیت اتوایمیون)، ANA مثبت دیده میشود و این روش برای افتراق کمک میکند. با این حال، سفارش آزمایش باید بر اساس علائم بالینی باشد تا از آزمایشهای غیرضروری جلوگیری شود، زیرا ویژگی روش پایین است (مثبت کاذب در 20-30% موارد).
## تفسیر نتایج
تفسیر نتایج IIF نیاز به دانش بالینی و آزمایشگاهی دارد، زیرا نتایج نه تنها بر اساس مثبت/منفی، بلکه تیتر، الگو و همبستگی با علائم بیمار ارزیابی میشود. کمیته بینالمللی ICAP الگوها را به سه گروه هستهای، سیتوپلاسمی و میتوزی تقسیم کرده است. تیتر ≥1:80 معمولاً مثبت در نظر گرفته میشود، اما این بسته به آزمایشگاه متفاوت است (برخی 1:40 را آستانه قرار میدهند).
### تفسیر کلی
– نتیجه منفی: عدم فلورسانس یا تیتر <1:80 نشاندهنده عدم وجود ANA قابل توجه است. با این حال، منفی کاذب ممکن است در بیماران تحت درمان با کورتیکواستروئیدها یا روشهای با حساسیت پایین رخ دهد. در چنین مواردی، اگر علائم قوی باشد، آزمایشهای خاصتر توصیه میشود.
– نتیجه مثبت: تیتر ≥1:80 با الگوی مشخص. تیترهای بالاتر (مانند 1:640 یا بیشتر) نشاندهنده فعالیت خودایمنی قویتر هستند، اما تیتر به تنهایی تشخیصی نیست و باید با علائم همخوانی داشته باشد. مثبت کاذب در 3-15% افراد سالم (بیشتر زنان، سالمندان یا افراد با عفونتهای ویروسی) دیده میشود.
### الگوهای فلورسانس و تفسیر بالینی
الگوها بر اساس توزیع فلورسانس طبقهبندی میشوند:
- الگوهای هستهای (AC-1 تا AC-28 بر اساس ICAP):
- هموژن (AC-1): فلورسانس یکنواخت هسته؛ مرتبط با anti-dsDNA یا anti-histone؛ شایع در SLE دارویی یا SLE (حساسیت 70-80% برای SLE). تیتر بالا پیشآگهی بدتری نشان میدهد.
- خالدار درشت (AC-4): نقاط بزرگ در هسته؛ مرتبط با anti-SSA/Ro، anti-SSB/La؛ شایع در سندرم شوگرن اولیه (60-70%) یا SLE زیرکوتانئوس.
- خالدار ریز (AC-5): نقاط ریز پراکنده؛ مرتبط با anti-Sm، anti-RNP؛ در SLE (20-30%) یا MCTD (90%) دیده میشود و نیاز به آزمایش ENA دارد.
- نوکلئولار (AC-8-10): فلورسانس نوکلئولوس؛ مرتبط با anti-PM-Scl، anti-fibrillarin؛ در اسکلرودرمی (20-30%) یا میوپاتیها؛ الگوی هموژن نوکلئولار با پیشآگهی بهتر مرتبط است.
- سانترومر (AC-3): نقاط گسسته در هسته و میتوز؛ مرتبط با anti-CENP-B؛ شایع در اسکلرودرمی محدود (CREST syndrome، 70-80%)؛ پیشآگهی خوب با درگیری کمتر ارگانها.
- الگوهای سیتوپلاسمی (AC-15 تا AC-23):
- خالدار سیتوپلاسمی (AC-18): نقاط در سیتوپلاسم؛ مرتبط با anti-Jo-1؛ در میوپاتیهای التهابی (پولیمیوزیت، 20-30%).
- فیبریلار (AC-15-17): الگوهای خطی؛ مرتبط با anti-actin یا anti-cytokeratin؛ در هپاتیت اتوایمیون یا بیماریهای کبدی.
- الگوهای میتوزی (AC-24 تا AC-28): فلورسانس در سلولهای میتوزی؛ مانند الگوی سانتریول (AC-24) مرتبط با anti-ninein؛ نادر اما در اسکلرودرمی دیده میشود.
### الگوهای پیچیده و ترکیبی
در حدود 20-30% موارد، الگوهای ترکیبی (مانند هموژن + خالدار) دیده میشود که نشاندهنده چندین اتوآنتیبادی است. برای مثال، هموژن + سانترومر ممکن است SLE با ویژگیهای اسکلرودرمی را پیشنهاد کند. تفسیر باید شامل توضیح الگوها، تیتر و پیشنهاد آزمایشهای بعدی باشد.
### محدودیتها در تفسیر
– عوامل تأثیرگذار: سن (مثبت کاذب در سالمندان)، عفونتها (مثبت موقت)، داروها (مثبت کاذب هموژن). تیترها ممکن است با درمان کاهش نیابند، پس برای نظارت مناسب نیست.
– همبستگی بالینی: نتیجه مثبت بدون علائم، بیماری را تأیید نمیکند. ویژگی پایین (60-80%) نیاز به آزمایشهای تکمیلی دارد.
– استانداردسازی: واریانس بین آزمایشگاهها؛ استفاده از ICAP برای گزارش یکنواخت توصیه میشود.
این مقاله برای اهداف آموزشی است؛ برای کاربرد بالینی، با پزشک مشورت کنید.
خطاهای شایع آزمایشگاهی
اجرای صحیح مراحل آزمایش برای دستیابی به نتایج دقیق و قابل اعتماد ضروری است. برخی از خطاهای رایج عبارتند از:
- خشک شدن سوبسترا هنگام انکوباسیون: باعث از دست رفتن آنتیژنها و ایجاد نتایج منفی کاذب میشود.
- استفاده از سرم همولیز یا لیپمیک: میتواند باعث فلورسانس زمینهای و اختلال در مشاهده شود.
- شستشوی ناکافی یا شدید: شستشوی ناکافی سیگنال زمینه را افزایش میدهد و شستشوی شدید باعث کنده شدن سلولها از سوبسترا میشود.
- استفاده از میکروسکوپ با لامپ ضعیف یا فیلتر نامناسب: شدت فلورسانس را کاهش داده و مانع شناسایی دقیق الگوها میشود.
استاندارد گزارشدهی بر اساس ICAP
کمیته بینالمللی ICAP (International Consensus on ANA Patterns) یک سیستم استاندارد برای نامگذاری و گزارش الگوهای فلورسانس ارائه کرده است. گزارش باید شامل تیتر، نوع الگو (به همراه کد AC) و در صورت نیاز توصیه برای آزمایشهای تکمیلی باشد.
| الگو | کد ICAP | آنتیبادیهای محتمل | بیماریهای مرتبط |
|---|---|---|---|
| هموژن | AC-1 | Anti-dsDNA، Anti-histone | SLE، لوپوس دارویی |
| خالدار درشت | AC-4 | Anti-SSA/Ro، Anti-SSB/La | شوگرن، SLE |
| خالدار ریز | AC-5 | Anti-Sm، Anti-RNP | SLE، MCTD |
| سانترومر | AC-3 | Anti-CENP-B | اسکلرودرمی محدود (CREST) |
| نوکلئولار | AC-8 تا AC-10 | Anti-PM-Scl، Anti-fibrillarin | اسکلرودرمی، میوپاتیها |
| سیتوپلاسمی (خالدار) | AC-18 | Anti-Jo-1 | پولیمیوزیت، درماتومیوزیت |
مقایسه روش IIF با روشهای جایگزین (ELISA و Multiplex assays)
در جدول زیر مقایسهای سریع بین IIF، ELISA و Multiplex آورده شده است تا کارشناسان بتوانند مزایا و محدودیتها را ارزیابی کنند.
| روش | مزایا | محدودیتها |
|---|---|---|
| IIF روی HEp-2 | حساسیت بالا، شناسایی الگوهای متنوع، استاندارد طلایی | نیاز به اپراتور ماهر، تفسیر ذهنی، زمانبر |
| ELISA | قابلیت کمیسازی، خودکارسازی آسان | محدود به آنتیژنهای مشخص، حساسیت کمتر برای طیف کامل ANA |
| Multiplex (مثلاً Luminex) | تشخیص همزمان چندین آنتیبادی، دقت و بازده بالا | هزینه بالا، نیاز به تجهیزات تخصصی، پیچیدگی تحلیل |
کیفیت و ایمنی
- رعایت استاندارد ISO 15189 برای تضمین کیفیت نتایج آزمایش الزامی است.
- استفاده از کنترل کیفی داخلی و خارجی (EQA) برای اعتبارسنجی نتایج توصیه میشود.
- در هنگام کار با سرم بیماران، رعایت اصول ایمنی زیستی سطح 2 (BSL-2) ضروری است (دستکش، روپوش، محافظ چشم).
جمعبندی عملی برای کارشناسان — چکلیست نهایی روش انجام آزمایش ANA
چکلیست اجرای آزمایش:
- Preparation: آمادهسازی نمونه سرم و اسلایدهای HEp-2
- Incubation: انکوباسیون با سرم بیمار و آنتیبادی ثانویه فلورسانت
- Wash: شستشوی دقیق برای حذف اتصالهای غیر اختصاصی
- Detection: مونتینگ و مشاهده زیر میکروسکوپ فلورسانس
- Interpretation: تعیین تیتر، الگو و ثبت نتیجه مطابق ICAP
توصیه برای گزارشدهی استاندارد: ذکر تیتر (مثلاً 1:320)، ذکر الگو با کد ICAP (مثلاً Homogeneous, AC-1) و در صورت لزوم، پیشنهاد آزمایشهای تکمیلی (مانند anti-dsDNA یا ENA profile).
سوالات رایج (FAQ) در مورد روش انجام آزمایش ANA
1. روش ANA چیست؟
آزمایشی برای شناسایی آنتیبادیهای ضد هستهای با روش ایمونوفلورسانس غیرمستقیم (IIF) روی سوبستراهای سلولی مانند HEp-2.
2. چرا سلول HEp-2 استفاده میشود؟
به دلیل هسته بزرگ و بیان بیش از 150 آنتیژن هستهای و سیتوپلاسمی که امکان مشاهده الگوهای مختلف ANA را فراهم میکند.
3. تیتر ANA چگونه گزارش میشود؟
به صورت رقت سرم تا بالاترین رفتی که الگو قابل مشاهده است (مثلاً 1:80، 1:160، 1:320).
4. حساسیت و اختصاصیت روش IIF چقدر است؟
حساسیت بالا برای برخی بیماریها (برای مثال >95% برای SLE)، اما اختصاصیت بسته به الگو و جمعیت متفاوت است و ممکن است با ELISA متفاوت باشد.
5. خطاهای شایع در آزمایش ANA کدامند؟
خشک شدن سوبسترا، استفاده از سرم همولیز/لیپمیک، شستشوی ناکافی یا شدید، و میکروسکوپ یا فیلتر نامناسب.
6. ICAP چیست و چه کاربردی دارد؟
کمیته بینالمللی ICAP سیستم استانداردی برای طبقهبندی و گزارش الگوهای ANA ارائه میدهد تا گزارشدهی یکنواخت و مقایسهپذیر شود.
7. تفاوت IIF با ELISA و Multiplex چیست؟
IIF حساستر و قادر به شناسایی الگوها است ولی نیازمند اپراتور ماهر؛ ELISA کمیتر و برای آنتیژنهای مشخص مناسبتر است؛ Multiplex امکان تشخیص همزمان چند آنتیبادی را میدهد ولی هزینه و پیچیدگی بالاتری دارد.
8. آیا ANA مثبت همیشه نشاندهنده بیماری خودایمنی است؟
خیر؛ ANA مثبت ممکن است در افراد سالم، سالمندان یا پس از عفونتهای ویروسی دیده شود. تفسیر باید با توجه به علائم بالینی انجام شود.
9. چگونه کیفیت آزمایش را تضمین کنیم؟
با اجرای پروتکلهای کنترل کیفی داخلی، شرکت در برنامههای EQA و رعایت استاندارد ISO 15189 و آموزش اپراتورها.
10. گزارش نهایی آزمایش ANA چه مواردی را باید شامل شود؟
تیتر، الگو (با کد ICAP)، تفسیر خلاصه و در صورت لزوم، پیشنهاد آزمایشهای تکمیلی (anti-dsDNA، ENA profile و …).
11. بهترین رفت اولیه برای غربالگری چیست؟
آستانههای متفاوت هستند اما بسیاری از آزمایشگاهها 1:80 را بهعنوان آستانه مثبت در نظر میگیرند؛ برخی 1:40 را به کار میبرند. استاندارد آزمایشگاه خود را مدنظر قرار دهید.
12. آیا تیتر ANA برای پیگیری درمان مناسب است؟
معمولاً نه؛ تیتر ANA ممکن است با درمان تغییرات کمی داشته باشد و برای مانیتورینگ درمان گزینهی ایدهآلی نیست؛ آزمایشهای اختصاصیتر مانند anti-dsDNA ممکن است بهتر باشند.